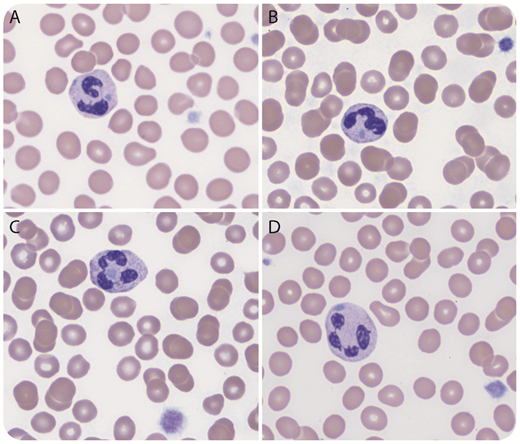
A 12-month-old previously healthy boy with a recent history of viral infection was found to have worsening thrombocytopenia (platelet count, 21-78 × 109/L). Immature platelet fraction was 51% (reference range: 0-7%). Red blood cells and white blood cells were within normal limits. Peripheral blood smear showed markedly reduced platelets that were mostly large in size. There were frequent neutrophils with randomly distributed well-defined Döhle body–like inclusions (panels A-D; Wright’s stain, original magnification ×1000). Some inclusions were located between the lobes (panel C). There was no toxic granulation or cytoplasmic vacuolation. Next gene sequencing identified a heterozygous pathogenic frameshift variant in MYH9, c.5830del (p.Asp1944ThrfsTer4), which confirmed the diagnosis of a MYH9-related disorder previously known as May-Hegglin anomaly. / Thrombocytopenia is quite common in children with infection or other medical conditions. Careful examination of PS is important for determining the causes. Döhle bodies in toxic or activated neutrophils are usually small, peripherally located, and not well-defined. Frequent randomly distributed, well-defined neutrophil Döhle body-like inclusions with large platelets should immediately raise concern for a MYH9-related disorder. A MYH9-related disorder also should be considered when immature platelet fraction is significantly increased (>40%), although mildly increased immature platelet fraction is commonly seen in conditions with increased platelet destruction/consumption, such as immune thrombocytopenia.

A 12-month-old previously healthy boy with a recent history of viral infection was found to have worsening thrombocytopenia (platelet count, 21-78 × 109/L). Immature platelet fraction was 51% (reference range: 0-7%). Red blood cells and white blood cells were within normal limits. Peripheral blood smear showed markedly reduced platelets that were mostly large in size. There were frequent neutrophils with randomly distributed well-defined Döhle body–like inclusions (panels A-D; Wright’s stain, original magnification ×1000). Some inclusions were located between the lobes (panel C). There was no toxic granulation or cytoplasmic vacuolation. Next gene sequencing identified a heterozygous pathogenic frameshift variant in MYH9, c.5830del (p.Asp1944ThrfsTer4), which confirmed the diagnosis of a MYH9-related disorder previously known as May-Hegglin anomaly.
Thrombocytopenia is quite common in children with infection or other medical conditions. Careful examination of PS is important for determining the causes. Döhle bodies in toxic or activated neutrophils are usually small, peripherally located, and not well-defined. Frequent randomly distributed, well-defined neutrophil Döhle body-like inclusions with large platelets should immediately raise concern for a MYH9-related disorder. A MYH9-related disorder also should be considered when immature platelet fraction is significantly increased (>40%), although mildly increased immature platelet fraction is commonly seen in conditions with increased platelet destruction/consumption, such as immune thrombocytopenia.
A 12-month-old previously healthy boy with a recent history of viral infection was found to have worsening thrombocytopenia (platelet count, 21-78 × 109/L). Immature platelet fraction was 51% (reference range: 0-7%). Red blood cells and white blood cells were within normal limits. Peripheral blood smear showed markedly reduced platelets that were mostly large in size. There were frequent neutrophils with randomly distributed well-defined Döhle body–like inclusions (panels A-D; Wright’s stain, original magnification ×1000). Some inclusions were located between the lobes (panel C). There was no toxic granulation or cytoplasmic vacuolation. Next gene sequencing identified a heterozygous pathogenic frameshift variant in MYH9, c.5830del (p.Asp1944ThrfsTer4), which confirmed the diagnosis of a MYH9-related disorder previously known as May-Hegglin anomaly.
Thrombocytopenia is quite common in children with infection or other medical conditions. Careful examination of PS is important for determining the causes. Döhle bodies in toxic or activated neutrophils are usually small, peripherally located, and not well-defined. Frequent randomly distributed, well-defined neutrophil Döhle body-like inclusions with large platelets should immediately raise concern for a MYH9-related disorder. A MYH9-related disorder also should be considered when immature platelet fraction is significantly increased (>40%), although mildly increased immature platelet fraction is commonly seen in conditions with increased platelet destruction/consumption, such as immune thrombocytopenia.
For additional images, visit the ASH Image Bank, a reference and teaching tool that is continually updated with new atlas and case study images. For more information, visit http://imagebank.hematology.org.